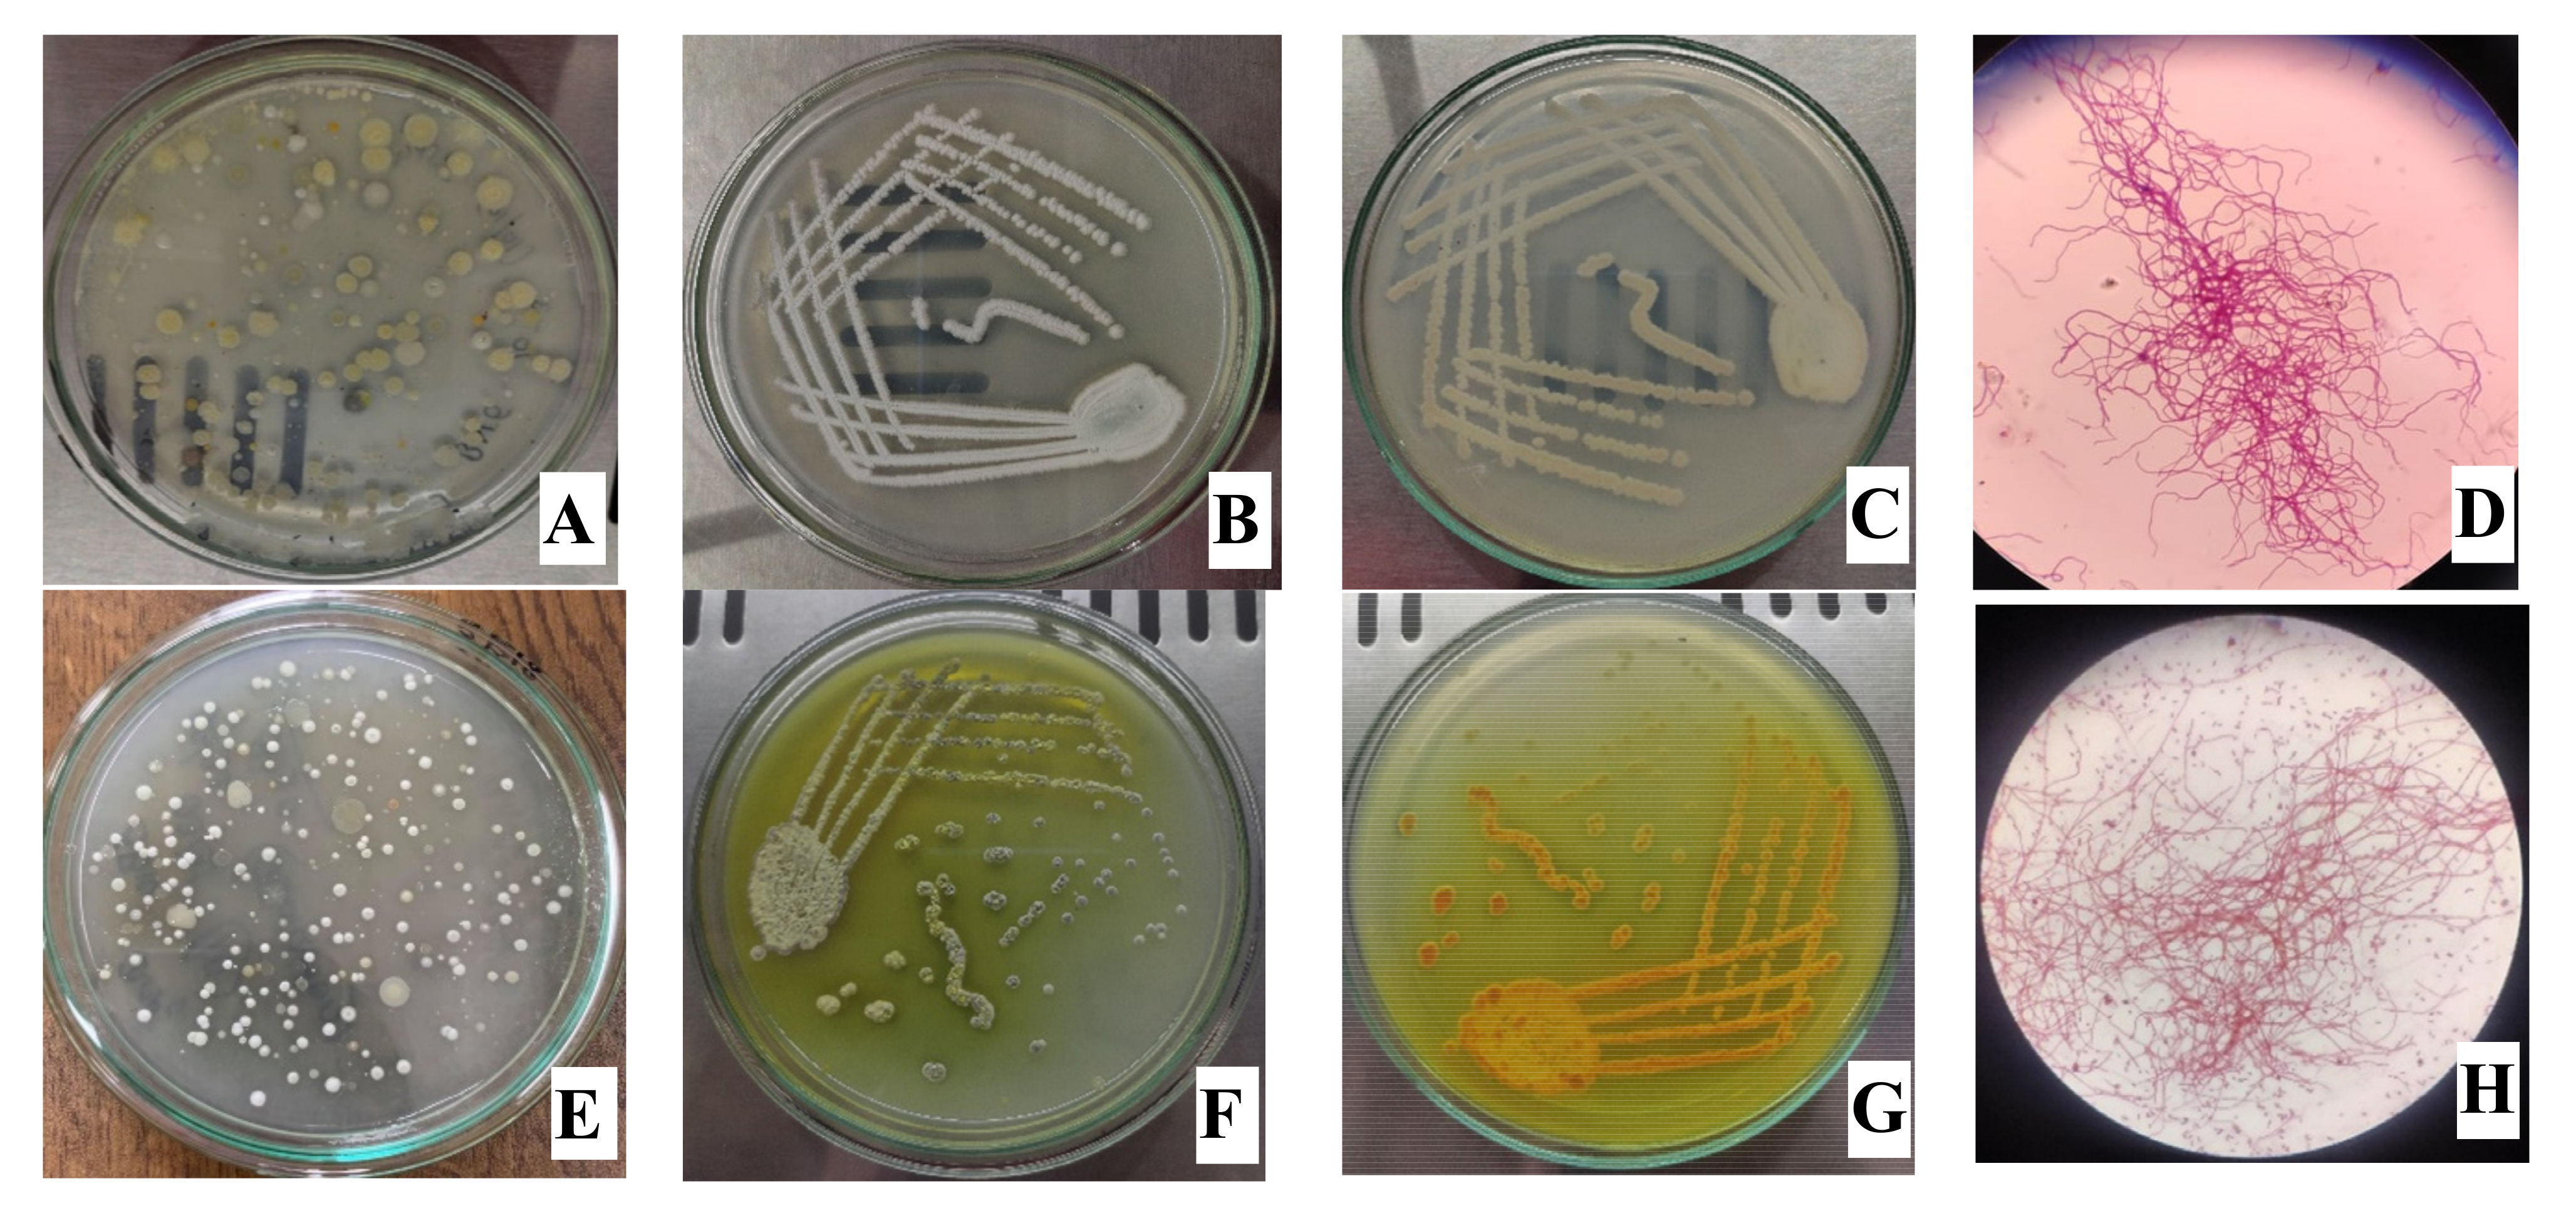
Processes 10 01173 g002 Processes 10 01173 g002

Untargeted Metabolomics of Streptomyces Species Isolated from Soils of Nepal
Abstract
1. Introduction
2. Materials and Methods
2.1. Soil Samples Collection and Isolation of Actinomycetes
2.2. Morphological and Molecular Characterization of Actinomycetes
2.2.1. Macroscopic and Microscopic Characterization
2.2.2. Extraction of Genomic DNA and 16S rRNA Amplification
2.2.3. Sequence Analysis
2.3. Flask Fermentation and Extraction of Bioactive Metabolites
2.4. Antibacterial Susceptibility Test
2.5. GNPS-Based Molecular Networking
2.6. Metabolic Profiling
3. Results
3.1. Macroscopic and Microscopic Characterization of Actinomycetes
3.2. Extraction of Genomic DNA and PCR
3.3. Sequence Analysis
3.4. Antibacterial Susceptibility Test
3.5. GNPS-Based Molecular Networking
3.6. Metabolic Profiling
4. Discussion
5. Conclusions
Supplementary Materials
Author Contributions
Funding
Institutional Review Board Statement
Informed Consent Statement
Data Availability Statement
Acknowledgments
Conflicts of Interest
References
- Hutchings, M.I.; Truman, A.W.; Wilkinson, B. Antibiotics: Past, Present and Future. Curr. Opin. Microbiol. 2019, 51, 72–80. [Google Scholar] [CrossRef]
- Uddin, T.M.; Chakraborty, A.J.; Khusro, A.; Zidan, B.R.M.; Mitra, S.; Emran, T.B.; Dhama, K.; Ripon, M.K.H.; Gajdács, M.; Sahibzada, M.U.K.; et al. Antibiotic Resistance in Microbes: History, Mechanisms, Therapeutic Strategies and Future Prospects. J. Infect. Public Health 2021, 14, 1750–1766. [Google Scholar] [CrossRef]
- Hug, J.J.; Bader, C.D.; Remškar, M.; Cirnski, K.; Müller, R. Concepts and Methods to Access Novel Antibiotics from Actinomycetes. Antibiotics 2018, 7, 44. [Google Scholar] [CrossRef]
- Lima, R.; Del Fiol, F.S.; Balcão, V.M. Prospects for the Use of New Technologies to Combat Multidrug-Resistant Bacteria. Front. Pharmacol. 2019, 10, 692. [Google Scholar] [CrossRef]
- Tavares, L.S.; Silva, C.S.F.; Souza, V.C.; Silva, V.L.; Diniz, C.G.; Santos, M.D.O. Strategies and Molecular Tools to Fight Antimicrobial Resistance: Resistome, Transcriptome, and Antimicrobial Peptides. Front. Microbiol. 2013, 4, 412. [Google Scholar] [CrossRef]
- WHO. Antimicrobial Resistance. Available online: https://www.who.int/news-room/fact-sheets/detail/antimicrobial-resistance (accessed on 28 March 2021).
- WHO. New Report Calls for Urgent Action to Avert Antimicrobial Resistance Crisis. Available online: https://www.who.int/news/item/29-04-2019-new-report-calls-for-urgent-action-to-avert-antimicrobial-resistance-crisis (accessed on 23 January 2022).
- Levy, S.B.; Marshall, B. Antibacterial Resistance Worldwide: Causes, Challenges and Responses. Nat. Med. 2004, 10, S122–S129. [Google Scholar] [CrossRef]
- Chokshi, A.; Sifri, Z.; Cennimo, D.; Horng, H. Global Contributors to Antibiotic Resistance. J. Glob. Infect. Dis. 2019, 11, 36–42. [Google Scholar] [CrossRef]
- Majer, H.M.; Ehrlich, R.L.; Ahmed, A.; Earl, J.P.; Ehrlich, G.D.; Beld, J. Whole Genome Sequencing of Streptomyces Actuosus ISP-5337, Streptomyces Sioyaensis B-5408, and Actinospica Acidiphila B-2296 Reveals Secondary Metabolomes with Antibiotic Potential. Biotechnol. Rep. 2021, 29, e00596. [Google Scholar] [CrossRef]
- Van der Meij, A.; Worsley, S.F.; Hutchings, M.I.; van Wezel, G.P. Chemical Ecology of Antibiotic Production by Actinomycetes. FEMS Microbiol. Rev. 2017, 41, 392–416. [Google Scholar] [CrossRef]
- Barka, E.A.; Vatsa, P.; Sanchez, L.; Gaveau-Vaillant, N.; Jacquard, C.; Meier-Kolthoff, J.P.; Klenk, H.-P.; Clément, C.; Ouhdouch, Y.; van Wezel, G.P. Taxonomy, Physiology, and Natural Products of Actinobacteria. Microbiol. Mol. Biol. Rev. 2016, 80, 1–43. [Google Scholar] [CrossRef]
- Hopwood, D.A. Highlights of Streptomyces Genetics. Heredity 2019, 123, 23–32. [Google Scholar] [CrossRef] [PubMed]
- Liu, Y.; Tong, Z.; Shi, J.; Li, R.; Upton, M.; Wang, Z. Drug Repurposing for Next-Generation Combination Therapies against Multidrug-Resistant Bacteria. Theranostics 2021, 11, 4910–4928. [Google Scholar] [CrossRef] [PubMed]
- De Simeis, D.; Serra, S. Actinomycetes: A Never-Ending Source of Bioactive Compounds—An Overview on Antibiotics Production. Antibiotics 2021, 10, 483. [Google Scholar] [CrossRef]
- Colwell, R.R. Microbial Diversity: The Importance of Exploration and Conservation. J. Ind. Microbiol. Biotechnol. 1997, 18, 302–307. [Google Scholar] [CrossRef]
- Overmann, J.; Abt, B.; Sikorski, J. Present and Future of Culturing Bacteria. Annu. Rev. Microbiol. 2017, 71, 711–730. [Google Scholar] [CrossRef] [PubMed]
- Sant’Anna, F.H.; Reiter, K.C.; Fátima Almeida, P.; Pereira Passaglia, L.M. 2020 Systematic Review of Descriptions of Novel Bacterial Species: Evaluation of the Twenty-First Century Taxonomy through Text Mining. Int. J. Syst. Evol. Microbiol. 2020, 70, 2925–2936. [Google Scholar] [CrossRef]
- Onaka, H. Novel Antibiotic Screening Methods to Awaken Silent or Cryptic Secondary Metabolic Pathways in Actinomycetes. J. Antibiot. 2017, 70, 865–870. [Google Scholar] [CrossRef]
- Liu, R.; Bao, Z.-X.; Zhao, P.-J.; Li, G.-H. Advances in the Study of Metabolomics and Metabolites in Some Species Interactions. Molecules 2021, 26, 3311. [Google Scholar] [CrossRef]
- Idle, J.R.; Gonzalez, F.J. Metabolomics. Cell Metab. 2007, 6, 348–351. [Google Scholar] [CrossRef]
- Zhang, X.; Li, Q.; Xu, Z.; Dou, J. Mass Spectrometry-Based Metabolomics in Health and Medical Science: A Systematic Review. RSC Adv. 2020, 10, 3092–3104. [Google Scholar] [CrossRef]
- Xiao, J.F.; Zhou, B.; Ressom, H.W. Metabolite Identification and Quantitation in LC-MS/MS-Based Metabolomics. Trends Anal. Chem. 2012, 32, 1–14. [Google Scholar] [CrossRef] [PubMed]
- Dunn, W.B.; Hankemeier, T. Mass Spectrometry and Metabolomics: Past, Present and Future. Metabolomics 2013, 9, 1–3. [Google Scholar] [CrossRef]
- Basilio, A.; González, I.; Vicente, M.F.; Gorrochategui, J.; Cabello, A.; González, A.; Genilloud, O. Patterns of Antimicrobial Activities from Soil Actinomycetes Isolated under Different Conditions of PH and Salinity. J. Appl. Microbiol. 2003, 95, 814–823. [Google Scholar] [CrossRef]
- Kharel, M.K.; Shepherd, M.D.; Nybo, S.E.; Smith, M.L.; Bosserman, M.A.; Rohr, J. Isolation of Streptomyces Species from Soil. Curr. Protoc. Microbiol. 2010, 19, 10E.4.1–10E.4.5. [Google Scholar] [CrossRef] [PubMed]
- Li, Q.; Chen, X.; Jiang, Y.; Jiang, C. Morphological Identification of Actinobacteria. Actinobacteria Basics Biotechnol. Appl. 2016, 2016, 59–86. [Google Scholar] [CrossRef]
- Bergey’s Manual of Systematic Bacteriology: Volume 5: The Actinobacteria. In Bergey’s Manual of Systematic Bacteriology, 2nd ed.; Whitman, W., Goodfellow, M., Kämpfer, P., Busse, H.-J., Trujillo, M., Ludwig, W., Suzuki, K., Parte, A., Eds.; Springer: New York, NY, USA, 2012; ISBN 978-0-387-95043-3. [Google Scholar]
- Tripathi, N.; Sapra, A. Gram Staining. In StatPearls; StatPearls Publishing: Treasure Island, FL, USA, 2022. [Google Scholar]
- Khadayat, K.; Sherpa, D.D.; Malla, K.P.; Shrestha, S.; Rana, N.; Marasini, B.P.; Khanal, S.; Rayamajhee, B.; Bhattarai, B.R.; Parajuli, N. Molecular Identification and Antimicrobial Potential of Streptomyces Species from Nepalese Soil. Int. J. Microbiol. 2020, 2020, 8817467. [Google Scholar] [CrossRef]
- Johnson, M.; Zaretskaya, I.; Raytselis, Y.; Merezhuk, Y.; McGinnis, S.; Madden, T.L. NCBI BLAST: A Better Web Interface. Nucleic Acids Res. 2008, 36, W5–W9. [Google Scholar] [CrossRef]
- Tamura, K.; Stecher, G.; Kumar, S. MEGA11: Molecular Evolutionary Genetics Analysis Version 11. Mol. Biol. Evol. 2021, 38, 3022–3027. [Google Scholar] [CrossRef]
- Gislin, D.; Sudarsanam, D.; Antony Raj, G.; Baskar, K. Antibacterial Activity of Soil Bacteria Isolated from Kochi, India and Their Molecular Identification. J. Genet. Eng. Biotechnol. 2018, 16, 287–294. [Google Scholar] [CrossRef]
- Aryal, B.; Adhikari, B.; Aryal, N.; Bhattarai, B.R.; Khadayat, K.; Parajuli, N. LC-HRMS Profiling and Antidiabetic, Antioxidant, and Antibacterial Activities of Acacia Catechu (L.f.) Willd. BioMed Res. Int. 2021, 2021, 7588711. [Google Scholar] [CrossRef]
- Wang, M.; Carver, J.J.; Phelan, V.V.; Sanchez, L.M.; Garg, N.; Peng, Y.; Nguyen, D.D.; Watrous, J.; Kapono, C.A.; Luzzatto-Knaan, T.; et al. Sharing and Community Curation of Mass Spectrometry Data with Global Natural Products Social Molecular Networking. Nat. Biotechnol. 2016, 34, 828–837. [Google Scholar] [CrossRef] [PubMed]
- Bhattarai, K.; Paudel, B.; Dahal, S.; Yadav, P.; Aryal, N.; Baral, B.; Bhattarai, H.D. Bioprospecting the Metabolome of Plant Urtica Dioica, L.: A Fast Dereplication and Annotation Workflow in Plant Metabolomics. Evid. Based Complementary Altern. Med. 2022, 2022, 3710791. [Google Scholar] [CrossRef] [PubMed]
- Handayani, I.; Saad, H.; Ratnakomala, S.; Lisdiyanti, P.; Kusharyoto, W.; Krause, J.; Kulik, A.; Wohlleben, W.; Aziz, S.; Gross, H.; et al. Mining Indonesian Microbial Biodiversity for Novel Natural Compounds by a Combined Genome Mining and Molecular Networking Approach. Mar. Drugs 2021, 19, 316. [Google Scholar] [CrossRef] [PubMed]
- Van Santen, J.A.; Jacob, G.; Singh, A.L.; Aniebok, V.; Balunas, M.J.; Bunsko, D.; Neto, F.C.; Castaño-Espriu, L.; Chang, C.; Clark, T.N.; et al. The Natural Products Atlas: An Open Access Knowledge Base for Microbial Natural Products Discovery. ACS Cent. Sci. 2019, 5, 1824–1833. [Google Scholar] [CrossRef] [PubMed]
- Van Santen, J.A.; Poynton, E.F.; Iskakova, D.; McMann, E.; Alsup, T.A.; Clark, T.N.; Fergusson, C.H.; Fewer, D.P.; Hughes, A.H.; McCadden, C.A.; et al. The Natural Products Atlas 2.0: A Database of Microbially-Derived Natural Products. Nucleic Acids Research 2022, 50, D1317–D1323. [Google Scholar] [CrossRef]
- Dührkop, K.; Fleischauer, M.; Ludwig, M.; Aksenov, A.A.; Melnik, A.V.; Meusel, M.; Dorrestein, P.C.; Rousu, J.; Böcker, S. SIRIUS 4: A Rapid Tool for Turning Tandem Mass Spectra into Metabolite Structure Information. Nat. Methods 2019, 16, 299–302. [Google Scholar] [CrossRef]
- Dührkop, K.; Shen, H.; Meusel, M.; Rousu, J.; Böcker, S. Searching Molecular Structure Databases with Tandem Mass Spectra Using CSI:FingerID. Proc. Natl. Acad. Sci. USA 2015, 112, 12580–12585. [Google Scholar] [CrossRef]
- Qureshi, K.A.; Bholay, A.D.; Rai, P.K.; Mohammed, H.A.; Khan, R.A.; Azam, F.; Jaremko, M.; Emwas, A.-H.; Stefanowicz, P.; Waliczek, M.; et al. Isolation, Characterization, Anti-MRSA Evaluation, and in-Silico Multi-Target Anti-Microbial Validations of Actinomycin X2 and Actinomycin D Produced by Novel Streptomyces Smyrnaeus UKAQ_23. Sci. Rep. 2021, 11, 14539. [Google Scholar] [CrossRef]
- Thomas, D.; Morris, M.; Curtis, J.M.; Boyd, R.K. Fragmentation Mechanisms of Protonated Actinomycins and Their Use in Structural Determination of Unknown Analogues. J. Mass Spectrom. 1995, 30, 1111–1125. [Google Scholar] [CrossRef]
- Paudel, B.; Maharjan, R.; Rajbhandari, P.; Aryal, N.; Aziz, S.; Bhattarai, K.; Baral, B.; Malla, R.; Bhattarai, H.D. Maculosin, a Non-Toxic Antioxidant Compound Isolated from Streptomyces Sp. KTM18. Pharm. Biol. 2021, 59, 931–934. [Google Scholar] [CrossRef]
- Wattana-Amorn, P.; Charoenwongsa, W.; Williams, C.; Crump, M.P.; Apichaisataienchote, B. Antibacterial Activity of Cyclo(L-Pro-L-Tyr) and Cyclo(D-Pro-L-Tyr) from Streptomyces Sp. Strain 22-4 against Phytopathogenic Bacteria. Nat. Prod. Res. 2016, 30, 1980–1983. [Google Scholar] [CrossRef] [PubMed]
- Zhen, X.; Gong, T.; Liu, F.; Zhang, P.-C.; Zhou, W.-Q.; Li, Y.; Zhu, P. A New Analogue of Echinomycin and a New Cyclic Dipeptide from a Marine-Derived Streptomyces Sp. LS298. Mar. Drugs 2015, 13, 6947–6961. [Google Scholar] [CrossRef] [PubMed]
- Li, B.; Chen, G.; Bai, J.; Jing, Y.-K.; Pei, Y.-H. A Bisamide and Four Diketopiperazines from a Marine-Derived Streptomyces Sp. J. Asian Nat. Prod. Res. 2011, 13, 1146–1150. [Google Scholar] [CrossRef] [PubMed]
- Pettit, G.R.; Du, J.; Pettit, R.K.; Richert, L.A.; Hogan, F.; Mukku, V.J.R.V.; Hoard, M.S. Antineoplastic Agents. 554. The Manitoba Bacterium Streptomyces Sp. J. Nat. Prod. 2006, 69, 804–806. [Google Scholar] [CrossRef]
- Le Goff, G.; Martin, M.-T.; Iorga, B.I.; Adelin, E.; Servy, C.; Cortial, S.; Ouazzani, J. Isolation and Characterization of Unusual Hydrazides from Streptomyces Sp. Impact of the Cultivation Support and Extraction Procedure. J. Nat. Prod. 2013, 76, 142–149. [Google Scholar] [CrossRef] [PubMed]
- Ren, J.; Liu, D.; Tian, L.; Wei, Y.; Proksch, P.; Zeng, J.; Lin, W. Venezuelines A-G, new Phenoxazine-Based Alkaloids and Aminophenols from Streptomyces Venezuelae and the Regulation of Gene Target Nur77. Bioorg. Med. Chem. Lett. 2013, 23, 301–304. [Google Scholar] [CrossRef]
- Bugni, T.S.; Woolery, M.; Kauffman, C.A.; Jensen, P.R.; Fenical, W. Bohemamines from a Marine-Derived Streptomyces Sp. J. Nat. Prod. 2006, 69, 1626–1628. [Google Scholar] [CrossRef]
- Vértesy, L.; Fehlhaber, H.-W.; Schulz, A. The Trehalase Inhibitor Salbostatin, a Novel Metabolite from Streptomyces Albus, ATCC21838. Angew. Chem. Int. Ed. 1994, 33, 1844–1846. [Google Scholar] [CrossRef]
- Shizuri, Y.; Ojika, M.; Yamada, K. Structure of an Antitumor Antibiotic, Reductiomycin. Tetrahedron Lett. 1981, 22, 4291–4294. [Google Scholar] [CrossRef]
- Lee, B.; Son, S.; Lee, J.K.; Jang, M.; Heo, K.T.; Ko, S.-K.; Park, D.-J.; Park, C.S.; Kim, C.-J.; Ahn, J.S.; et al. Isolation of New Streptimidone Derivatives, Glutarimide Antibiotics from Streptomyces Sp. W3002 Using LC-MS-Guided Screening. J. Antibiot. 2020, 73, 184–188. [Google Scholar] [CrossRef]
- Naganawa, H.; Wakashiro, T.; Yagi, A.; Kondo, S.; Takita, T. Deoxynybomycin from a Streptomyces. J. Antibiot. 1970, 23, 365–368. [Google Scholar] [CrossRef] [PubMed]
- Raju, R.; Gromyko, O.; Fedorenko, V.; Luzhetskyy, A.; Müller, R. Pimprinols A–C, from the Terrestrial Actinomycete, Streptomyces Sp. Tetrahedron Lett. 2012, 53, 3009–3011. [Google Scholar] [CrossRef]
- Hochlowski, J.E.; Andres, W.W.; Theriault, R.J.; Jackson, M.; McAlpine, J.B. Abbeymycin, a New Anthramycin-Type Antibiotic Produced by a Streptomycete. J. Antibiot. 1987, 40, 145–148. [Google Scholar] [CrossRef] [PubMed]
- Uotani, K.; Naganawa, H.; Kondo, S.; Aoyagi, T.; Umezawa, H. Structural Studies on Ebelactone A and B, Esterase Inhibitors Produced by Actinomycetes. J. Antibiot. 1982, 35, 1495–1499. [Google Scholar] [CrossRef] [PubMed]
- Abe, N.; Enoki, N.; Nakakita, Y.; Uchida, H.; Nakamura, T.; Munekata, M. Novel Cytocidal Compounds, Oxopropalines from Streptomyces Sp. G324 Producing Lavendamycin. II. Physico-Chemical Properties and Structure Elucidations. J. Antibiot. 1993, 46, 1678–1686. [Google Scholar] [CrossRef] [PubMed][Green Version]
- Teramura, K.; Orita, M.; Matsumoto, H.; Yasumuro, K.; Abe, K. Effects of Ym-51084 and Ym-51085, New Inhibitors Produced by Streptomyces Sp. Q21705, on Cathepsin, L. J. Enzym. Inhib. 1996, 11, 115–121. [Google Scholar] [CrossRef]
- Geiger, A.; Keller-Schierlein, W.; Brandl, M.; Zähner, H. Metabolites of Microorganisms. 247. Phenazines from Streptomyces Antibioticus, Strain Tü 2706. J. Antibiot. 1988, 41, 1542–1551. [Google Scholar] [CrossRef]
- Comin, J.; Keller-Schierlein, W. Stoffwechselprodukte von Actinomyceten. 19. Mitteilung N-Acetyl-tyramin. Helv. Chim. Acta 1959, 42, 1730–1732. [Google Scholar] [CrossRef]
- Banskota, A.H.; McAlpine, J.B.; Sørensen, D.; Aouidate, M.; Piraee, M.; Alarco, A.-M.; Omura, S.; Shiomi, K.; Farnet, C.M.; Zazopoulos, E. Isolation and Identification of Three New 5-Alkenyl-3,3(2H)-Furanones from Two Streptomyces Species Using a Genomic Screening Approach. J. Antibiot. 2006, 59, 168–176. [Google Scholar] [CrossRef]
- Wang, F.; Xu, M.; Li, Q.; Sattler, I.; Lin, W. P-Aminoacetophenonic Acids Produced by a Mangrove Endophyte Streptomyces Sp. (Strain HK10552). Molecules 2010, 15, 2782–2790. [Google Scholar] [CrossRef]
- Tan, L.T.-H.; Chan, K.-G.; Pusparajah, P.; Yin, W.-F.; Khan, T.M.; Lee, L.-H.; Goh, B.-H. Mangrove Derived Streptomyces Sp. MUM265 as a Potential Source of Antioxidant and Anticolon-Cancer Agents. BMC Microbiol. 2019, 19, 38. [Google Scholar] [CrossRef] [PubMed]
- Yang, S.W.; Cordell, G.A. Metabolism Studies of Indole Derivatives Using a Staurosporine Producer, Streptomyces Staurosporeus. J. Nat. Prod. 1997, 60, 44–48. [Google Scholar] [CrossRef] [PubMed]
- Řezanka, T.; Spížek, J.; Přikrylová, V.; Prell, A.; Dembitsky, V.M. Five New Derivatives of Nonactic and Homo-Nonactic Acids from Streptomyces Globisporus. Tetrahedron 2004, 60, 4781–4787. [Google Scholar] [CrossRef]
- Hosny, M.; Rosazza, J.P.N. Microbial Hydroxylation and Methylation of Genistein by Streptomycetes. J. Nat. Prod. 1999, 62, 1609–1612. [Google Scholar] [CrossRef]
- Tchize Ndejouong, B.L.S.; Sattler, I.; Dahse, H.-M.; Kothe, E.; Hertweck, C. Isoflavones with Unusually Modified B-Rings and Their Evaluation as Antiproliferative Agents. Bioorganic Med. Chem. Lett. 2009, 19, 6473–6476. [Google Scholar] [CrossRef]
- Fyans, J.K.; Altowairish, M.S.; Li, Y.; Bignell, D.R.D. Characterization of the Coronatine-Like Phytotoxins Produced by the Common Scab Pathogen Streptomyces Scabies. MPMI 2015, 28, 443–454. [Google Scholar] [CrossRef]
- Pérez-Picaso, L.; Olivo, H.F.; Argotte-Ramos, R.; Rodríguez-Gutiérrez, M.; Rios, M.Y. Linear and Cyclic Dipeptides with Antimalarial Activity. Bioorg. Med. Chem. Lett. 2012, 22, 7048–7051. [Google Scholar] [CrossRef]
- Smith, K.; White, R.L.; Le, Y.; Vining, L. Isolation of N-Acetyl-3,4-Dihydroxy-L-Phenylalanine from Streptomyces Akiyoshiensis. J. Natural Prod. 1995, 58, 1274–1277. [Google Scholar] [CrossRef]
- Ou, Y.; Huang, J.; Li, X.; Kang, Q.; Pan, Y. Three New 2,5-Diketopiperazines from the Fish Intestinal Streptomyces Sp. MNU FJ-36. Nat. Prod. Res. 2016, 30, 1771–1775. [Google Scholar] [CrossRef]
- Shamim Hossain, M.; Aslam Hossain, M.; Mukhlesur Rahman, M.; Mojid Mondol, M.A.; Bhuiyan, M.S.A.; Gray, A.I.; Flores, M.E.; Rashid, M.A. Amides from the Fungus Streptomyces Hygroscopicus and Their Antimicrobial Activity. Phytochemistry 2004, 65, 2147–2151. [Google Scholar] [CrossRef]
- Awa, Y.; Iwai, N.; Ueda, T.; Suzuki, K.; Asano, S.; Yamagishi, J.; Nagai, K.; Wachi, M. Isolation of a New Antibiotic, Alaremycin, Structurally Related to 5-Aminolevulinic Acid from Streptomyces Sp. A012304. Biosci. Biotechnol. Biochem. 2005, 69, 1721–1725. [Google Scholar] [CrossRef] [PubMed]
- Suhara, Y.; Maruyama, H.B.; Koto, Y.; Miyasaka, Y.; Yokose, K. A New Antibiotic, Fumaramidmycin. II. Isolation, Structure and Syntheses. J. Antibiot. 1975, 28, 648–655. [Google Scholar] [CrossRef] [PubMed]
- Sobin, B.A.; Tanner, F.W. Anisomycin,1 A New Anti-protozoab Antibiotics. J. Am. Chem. Soc. 1954, 76, 4053. [Google Scholar] [CrossRef]
- Sadovski, O.; Jaikaran, A.S.I.; Samanta, S.; Fabian, M.R.; Dowling, R.J.O.; Sonenberg, N.; Woolley, G.A. A Collection of Caged Compounds for Probing Roles of Local Translation in Neurobiology. Bioorg. Med. Chem. 2010, 18, 7746–7752. [Google Scholar] [CrossRef] [PubMed]
- Von Wittenau, M.S.; Els, H. The Structure of Indolmycin. J. Am. Chem. Soc. 1961, 83, 4678–4680. [Google Scholar] [CrossRef]
- Phay, N.; Yada, H.; Higashiyama, T.; Yokota, A.; Ichihara, A.; Tomita, F. NP-101A, Antifungal Antibiotic from Streptomyces Aurantiogriseus NPO-101. J. Antibiot. 1996, 49, 703–705. [Google Scholar] [CrossRef]
- Sakano, K.; Nakamura, S. New Antibiotics, Carbazomycins A and B. II. Structural Elucidation. J. Antibiot. 1980, 33, 961–966. [Google Scholar] [CrossRef]
- Fu, P.; Johnson, M.; Chen, H.; Posner, B.A.; MacMillan, J.B. Carpatamides A–C, Cytotoxic Arylamine Derivatives from a Marine-Derived Streptomyces Sp. J. Nat. Prod. 2014, 77, 1245–1248. [Google Scholar] [CrossRef]
- Shaaban, K.A.; Shepherd, M.D.; Ahmed, T.A.; Nybo, S.E.; Leggas, M.; Rohr, J. Pyramidamycins A-D and 3-Hydroxyquinoline-2-Carboxamide; Cytotoxic Benzamides from Streptomyces Sp. DGC1. J. Antibiot. 2012, 65, 615–622. [Google Scholar] [CrossRef]
- Jeong, S.-Y.; Shin, H.J.; Kim, T.S.; Lee, H.-S.; Park, S.; Kim, H.M. Streptokordin, a New Cytotoxic Compound of the Methylpyridine Class from a Marine-Derived Streptomyces Sp. KORDI-3238. J. Antibiot. 2006, 59, 234–240. [Google Scholar] [CrossRef] [PubMed]
- Zhou, H.; Yang, Y.; Yang, X.; Li, W.; Xiong, Z.; Zhao, L.; Xu, L.; Ding, Z. A New Cyclic Tetrapeptide from an Endophytic Streptomyces Sp. YIM67005. Nat. Prod. Res. 2014, 28, 318–323. [Google Scholar] [CrossRef] [PubMed]
- Takagi, M.; Motohashi, K.; Shin-ya, K. Isolation of 2 New Metabolites, JBIR-74 and JBIR-75, from the Sponge-Derived Aspergillus Sp. FS14. J. Antibiot. 2010, 63, 393–395. [Google Scholar] [CrossRef] [PubMed]
- Hosoya, Y.; Kameyama, T.; Naganawa, H.; Okami, Y.; Takeuchi, T. Anisomycin and New Congeners Active against Human Tumor Cell Lines. J. Antibiot. 1993, 46, 1300–1302. [Google Scholar] [CrossRef] [PubMed][Green Version]
- Zhang, J.; Wang, J.-D.; Liu, C.-X.; Yuan, J.-H.; Wang, X.-J.; Xiang, W.-S. A New Prenylated Indole Derivative from Endophytic Actinobacteria Streptomyces Sp. Neau-D50. Nat. Prod. Res. 2014, 28, 431–437. [Google Scholar] [CrossRef] [PubMed]
- Lambalot, R.H.; Cane, D.E. Isolation and Characterization of 10-Deoxymethynolide Produced by Streptomyces Venezuelae. J. Antibiot. 1992, 45, 1981–1982. [Google Scholar] [CrossRef][Green Version]
- Hawas, U.W.; Shaaban, M.; Shaaban, K.A.; Speitling, M.; Maier, A.; Kelter, G.; Fiebig, H.H.; Meiners, M.; Helmke, E.; Laatsch, H. Mansouramycins A−D, Cytotoxic Isoquinolinequinones from a Marine Streptomycete. J. Nat. Prod. 2009, 72, 2120–2124. [Google Scholar] [CrossRef]
- Li, Y.; Zheng, D.; Li, J.; Han, L.; Cui, X.; Lang, L.; Li, M.; Wang, Z.; Zhao, J.; Huang, X. Sannanine, a New Cytotoxic Alkaloid from Streptomyces Sannanensis. J. Antibiot. 2009, 62, 647–648. [Google Scholar] [CrossRef]
- Sorokina, M.; Steinbeck, C. Review on Natural Products Databases: Where to Find Data in 2020. J. Cheminform. 2020, 12, 20. [Google Scholar] [CrossRef]
- Newman, D.J.; Cragg, G.M. Natural Products as Sources of New Drugs from 1981 to 2014. J. Nat. Prod. 2016, 79, 629–661. [Google Scholar] [CrossRef]
- Jagannathan, S.V.; Manemann, E.M.; Rowe, S.E.; Callender, M.C.; Soto, W. Marine Actinomycetes, New Sources of Biotechnological Products. Mar. Drugs 2021, 19, 365. [Google Scholar] [CrossRef]
- Van der Heul, H.U.; Bilyk, B.L.; McDowall, K.J.; Seipke, R.F.; van Wezel, G.P. Regulation of Antibiotic Production in Actinobacteria: New Perspectives from the Post-Genomic Era. Nat. Prod. Rep. 2018, 35, 575–604. [Google Scholar] [CrossRef] [PubMed]
- Watve, M.G.; Tickoo, R.; Jog, M.M.; Bhole, B.D. How Many Antibiotics Are Produced by the Genus Streptomyces? Arch. Microbiol. 2001, 176, 386–390. [Google Scholar] [CrossRef] [PubMed]
- Bérdy, J. Bioactive Microbial Metabolites. J. Antibiot. 2005, 58, 1–26. [Google Scholar] [CrossRef] [PubMed]
- Sapkota, A.; Thapa, A.; Budhathoki, A.; Sainju, M.; Shrestha, P.; Aryal, S. Isolation, Characterization, and Screening of Antimicrobial-Producing Actinomycetes from Soil Samples. Int. J. Microbiol. 2020, 2020, 2716584. [Google Scholar] [CrossRef]
- Shrestha, B.; Nath, D.K.; Maharjan, A.; Poudel, A.; Pradhan, R.N.; Aryal, S. Isolation and Characterization of Potential Antibiotic-Producing Actinomycetes from Water and Soil Sediments of Different Regions of Nepal. Int. J. Microbiol. 2021, 2021, 5586165. [Google Scholar] [CrossRef]
- Baniya, A.; Singh, S.; Singh, M.; Nepal, P.; Adhikari, M.; Aryal, S.; Adhikari, A. Isolation and Screening of Antibiotics Producing Streptomyces Spp from the Soil Collected around the Root of Alnus Nepalensis from Godawari. Nepal J. Biotechnol. 2018, 6, 46–56. [Google Scholar] [CrossRef]
- Gurung, T.D.; Sherpa, C.; Agrawal, V.P.; Lekhak, B. Isolation and Characterization of Antibacterial Actinomycetes from Soil Samples of Kalapatthar, Mount Everest Region. Nepal J. Sci. Technol. 2009, 10, 173–182. [Google Scholar] [CrossRef]
- Yadav, J.; Shrestha, U.T.; Tiwari, K.B.; Sahukhal, G.S.; Agrawal, V.P. Streptomycin—Like Antibiotic from Streptomyces Spp. Isolated from Mount Everest Base Camp. Nepal J. Sci. Technol. 2008, 9, 73–77. [Google Scholar] [CrossRef][Green Version]
- Tortorella, E.; Tedesco, P.; Palma Esposito, F.; January, G.G.; Fani, R.; Jaspars, M.; De Pascale, D. Antibiotics from Deep-Sea Microorganisms: Current Discoveries and Perspectives. Mar. Drugs 2018, 16, 355. [Google Scholar] [CrossRef]
- Chandra, N.; Kumar, S. Antibiotics Producing Soil Microorganisms. In Antibiotics and Antibiotics Resistance Genes in Soils: Monitoring, Toxicity, Risk Assessment and Management; Hashmi, M.Z., Strezov, V., Varma, A., Eds.; Springer International Publishing: Cham, Switzerland, 2017; pp. 1–18. ISBN 978-3-319-66260-2. [Google Scholar]
- World Health Organization. Global Antimicrobial Resistance Surveillance System (GLASS) Report: Early Implementation 2020; World Health Organization: Geneva, Switzerland, 2020; ISBN 978-92-4-000558-7. [Google Scholar]
- Fernández-Martínez, L.T. Microbiology Today, Natural Products and Drug Discovery; Microbiology Society: London, UK, 2019; pp. 158–161. ISSN 1464-0570. [Google Scholar]
- Song, Z.; Hou, Y.; Yang, Q.; Li, X.; Wu, S. Structures and Biological Activities of Diketopiperazines from Marine Organisms: A Review. Mar. Drugs 2021, 19, 403. [Google Scholar] [CrossRef]
- Sioud, S.; Karray-Rebai, I.; Aouissaoui, H.; Aigle, B.; Bejar, S.; Mellouli, L. Targeted Gene Disruption of the Cyclo (L-Phe, L-Pro) Biosynthetic Pathway in Streptomyces Sp. US24 Strain. J. Biomed. Biotechnol. 2007, 2007, 91409. [Google Scholar] [CrossRef] [PubMed][Green Version]
- Huang, R.; Zhou, X.; Xu, T.; Yang, X.; Liu, Y. Diketopiperazines from Marine Organisms. Chem. Biodivers. 2010, 7, 2809–2829. [Google Scholar] [CrossRef] [PubMed]
- Hollstein, U. Actinomycin. Chemistry and Mechanism of Action. Chem. Rev. 1974, 74, 625–652. [Google Scholar] [CrossRef]
- Liu, M.; Jia, Y.; Xie, Y.; Zhang, C.; Ma, J.; Sun, C.; Ju, J. Identification of the Actinomycin D Biosynthetic Pathway from Marine-Derived Streptomyces Costaricanus SCSIO ZS0073. Mar. Drugs 2019, 17, 240. [Google Scholar] [CrossRef]
- Gerratana, B. Biosynthesis, Synthesis and Biological Activities of Pyrrolobenzodiazepines. Med. Res. Rev. 2012, 32, 254–293. [Google Scholar] [CrossRef]
- Donohue, J.; Smith, A.B.; Carroll, P.J. Crystal and Molecular Structure of Reductiomycin. J. Crystallogr. Spectrosc. Res. 1984, 14, 35–43. [Google Scholar] [CrossRef]
- Shimizu, K.; Tamura, G. Reductiomycin, a New Antibiotic. I. Taxonomy, Fermentation, Isolation, Characterization and Biological Activities. J. Antibiot. 1981, 34, 649–653. [Google Scholar] [CrossRef]
- Egawa, K.; Yamori, T.; Nosaka, C.; Kunimoto, S.; Takeuchi, T.; Nose, K. Deoxynybomycin Is a Selective Anti-Tumor Agent Inducing Apoptosis and Inhibiting Topoisomerase I. Biol. Pharm. Bull. 2000, 23, 1036–1040. [Google Scholar] [CrossRef]
- Räty, K.; Kantola, J.; Hautala, A.; Hakala, J.; Ylihonko, K.; Mäntsälä, P. Cloning and Characterization of Streptomyces Galilaeus Aclacinomycins Polyketide Synthase (PKS) Cluster. Gene 2002, 293, 115–122. [Google Scholar] [CrossRef]
- Fujii, I.; Ebizuka, Y. Anthracycline Biosynthesis in Streptomyces Galilaeus. Chem. Rev. 1997, 97, 2511–2524. [Google Scholar] [CrossRef]
- Harir, M.; Bendif, H.; Bellahcene, M.; Pogni, Z.F.R. Streptomyces Secondary Metabolites; IntechOpen: London, UK, 2018; ISBN 978-1-78984-615-7. [Google Scholar]
- Al-Ansari, M.; Kalaiyarasi, M.; Almalki, M.A.; Vijayaraghavan, P. Optimization of Medium Components for the Production of Antimicrobial and Anticancer Secondary Metabolites from Streptomyces Sp. AS11 Isolated from the Marine Environment. J. King Saud Univ. Sci. 2020, 32, 1993–1998. [Google Scholar] [CrossRef]
- Thakur, D.; Bora, T.C.; Bordoloi, G.N.; Mazumdar, S. Influence of Nutrition and Culturing Conditions for Optimum Growth and Antimicrobial Metabolite Production by Streptomyces Sp. 201. J. De Mycol. Médicale 2009, 19, 161–167. [Google Scholar] [CrossRef]
- VanderMolen, K.M.; Raja, H.A.; El-Elimat, T.; Oberlies, N.H. Evaluation of Culture Media for the Production of Secondary Metabolites in a Natural Products Screening Program. AMB Express 2013, 3, 71. [Google Scholar] [CrossRef] [PubMed]
- Arend, K.I.; Bandow, J.E. Influence of Amino Acid Feeding on Production of Calcimycin and Analogs in Streptomyces Chartreusis. Int. J. Environ. Res. Public Health 2021, 18, 8740. [Google Scholar] [CrossRef]
- Barbuto Ferraiuolo, S.; Cammarota, M.; Schiraldi, C.; Restaino, O.F. Streptomycetes as Platform for Biotechnological Production Processes of Drugs. Appl. Microbiol. Biotechnol. 2021, 105, 551–568. [Google Scholar] [CrossRef]
- Zhang, B.; Zhang, Y.-H.; Chen, Y.; Chen, K.; Jiang, S.-X.; Huang, K.; Liu, Z.-Q.; Zheng, Y.-G. Enhanced AmB Production in Streptomyces Nodosus by Fermentation Regulation and Rational Combined Feeding Strategy. Front. Bioeng. Biotechnol. 2020, 8, 597. [Google Scholar] [CrossRef]
- Nguyen, C.T.; Dhakal, D.; Pham, V.T.T.; Nguyen, H.T.; Sohng, J.-K. Recent Advances in Strategies for Activation and Discovery/Characterization of Cryptic Biosynthetic Gene Clusters in Streptomyces. Microorganisms 2020, 8, 616. [Google Scholar] [CrossRef]
- Wu, C.; Choi, Y.H.; van Wezel, G.P. Metabolic Profiling as a Tool for Prioritizing Antimicrobial Compounds. J. Ind. Microbiol. Biotechnol. 2016, 43, 299–312. [Google Scholar] [CrossRef]
- Ahmed, Y.; Rebets, Y.; Estévez, M.R.; Zapp, J.; Myronovskyi, M.; Luzhetskyy, A. Engineering of Streptomyces Lividans for Heterologous Expression of Secondary Metabolite Gene Clusters. Microb. Cell Factories 2020, 19, 5. [Google Scholar] [CrossRef]
- Winter, J.M.; Behnken, S.; Hertweck, C. Genomics-Inspired Discovery of Natural Products. Curr. Opin. Chem. Biol. 2011, 15, 22–31. [Google Scholar] [CrossRef]

| S.N. | Annotated Compounds | Accurate Mass (Da) | Precursor Ion | Adduct Type | Formula | Retention Time (Rt) (mins) | Ring and Double Bond Equivalents (RDB) | UV Absorption (nm) | Key Fragments | Error (ppm) | Sirius Score | References |
|---|---|---|---|---|---|---|---|---|---|---|---|---|
| 1 | Maculosin (Cyclo(L-pro-L-tyr) or Cyclo(D-Pro-L-Tyr)) | 260.12 | 261.12 | [M+H]+ | C9H16N4O5 | 12.9 | 8.0 | 220 | 233.12; 219.11 | −1.8 | 50.97% | [44,45] |
| 2 | Cyclo-(L-Pro-4-OH-L-Leu) | 226.13 | 227.13 | [M+H]+ | C11H18N2O3 | 10.9 | 4.0 | 214 | 209.12; 191.11; 149.10 | −1.4 | 28.96% | [46] |
| 3 | Cyclo(2-hydroxy-Pro-R-Leu); Cyclo(2-OH-D-Pro-L-Leu) | 226.13 | 227.13 | [M+H]+ | C11H18N2O3 | 10.9 | 4.0 | 214 | 209.12; 191.11; 149.10 | −1.4 | 32.20% | [47] |
| 4 | Cyclo-Pro-Val | 196.12 | 197.12 | [M+H]+ | C10H16N2O2 | 16.9 | 4 | 222 | 178.03 (M+H-NH3) | −4.2 | 93.47% | [48] |
| 5 | Geralcin E | 214.13 | 215.13 | [M+H]+ | C10H18N2O3 | 10.0 | 3.0 | 212 | 197.12; 169.13 | −1.1 | 33.17% | [49] |
| 6 | Venezueline B | 274.10 | 275.10 | [M+H]+ | C14H14N2O4 | 9.9 | 9.0 | 212 | 215.08; 187.08 | −0.9 | 28.53% | [50] |
| 7 | Venezueline G | 195.09 | 196.09 | [M+H]+ | C10H13NO3 | 9.3 | 5.0 | 212 | 174.97; 154.08 | −2.0 | 35.43% | [50] |
| 8 | Bohemamine | 262.13 | 263.13 | [M+H]+ | C14H18N2O3 | 12.3 | 7.0 | 218 | 136.07; 72.08 | −2.9 | 27.33% | [51] |
| 9 | Salbostatin | 321.14 | 322.15 | [M+H]+ | C13H23NO8 | 17.1 | 3.0 | 222 | 320.16; 304.19; 284.24; 279.08; 266.08; 261.10; 248.09 | −9.8 | 44.64% | [52] |
| 10 | Reductiomycin | 293.09 | 294.09 | [M+H]+ | C14H15NO6 | 15.7 | 8.0 | 222 | 250.08; 208.09; 177.10; 108.08; 81.06 | −1.4 | 31.05% | [53] |
| 11 | Streptimidone | 293.16 | 294.17 | [M+H]+ | C16H23NO4 | 13.5 | 6.0 | 218 | 208.09 | −1.5 | 41.38% | [54] |
| 12 | Deoxynybomycin | 282.10 | 283.10 | [M+H]+ | C16H14N2O3 | 11.5 | 11.0 | 194 | 269.12; 265.09; 243.09; 225.16; 206.08; 197.07; 183.07 | 4.7 | 29.77% | [55] |
| 13 | Pimprinol C | 242.11 | 243.11 | [M+H]+ | C14H14N2O2 | 13.5 | 9.0 | 220 | 215.11 | −2.0 | 22.99% | [56] |
| 14 | Abbeymycin | 248.12 | 249.12 | [M+H]+ | C13H16N2O3 | 12.1 | 7.0 | 194 | 227.02; 119.08; 83.04 | 4.2 | 26.24% | [57] |
| 15 | Ebelactone B | 352.26 | 353.26 | [M+H]+ | C21H36O4 | 35.9 | 4.0 | 230 | 86.06 | 4.3 | 58.96% | [58] |
| 16 | Oxopropaline D | 270.10 | 271.10 | [M+H]+ | C15H14N2O3 | 19.5 | 10.0 | 224 | 257.09 | −1.5 | 41.46% | [59] |
| 17 | Isovaleryl-D-Tyr-Val-D-Phe-ol (YM-51085) | 497.29 | 498.29 | [M+H]+ | C28H39N3O5 | 20.1 | 11.0 | 224 | 251.17; 220.13 | −0.9 | 62.69% | [60] |
| 18 | Saphenic acid methyl ester | 282.10 | 283.10 | [M+H]+ | C16H14N2O3 | 13.5 | 11.0 | 194 | 263.90; 244.93 | 4.8 | 35.48% | [61] |
| 19 | N-Acetyl-tyramine | 179.10 | 180.10 | [M+H]+ | C10H13NO2 | 12.8 | 5.0 | 218 | 121.06; 93.07 | −2.2 | 73.98% | [62] |
| 20 | 5-[(5E,7E,11E)-2,10-dihydroxy-9,11-dimethyltetradeca-5,7,11-trienyl]-2-hydroxy-2-(1-hydroxyethyl)-4-methylfuran-3-one (E-975) | 408.25 | 409.25 | [M+H]+ | C23H36O6 | 32.3 | 6.0 | 228 | 363.25; 307.18 | 4.6 | 34.56% | [63] |
| 21 | (2E)-11-(4′-aminophenyl)-5,9-O-cyclo-4,6,8-trimethyl-11-oxo-undec-2-enoic acid | 345.20 | 346.20 | [M+H]+ | C20H27NO4 | 13.7 | 8.0 | 220 | 331.08; 303.12; 266.25; 213.03 | −2.7 | 34.60% | [64] |
| 22 | Pyrrolo [1,2-a]pyrazine-1,4-dione, hexahydro-{Cyclo(Gly-Pro)} | 154.08 | 155.08 | [M+H]+ | C7H10N2O2 | 6.9 | 4.0 | 212 | 70.06 | −2.5 | 48.11% | [65] |
| 23 | (3aR,8aS)-1-acetyl-1,2,3,3a,8,8ahexahydropyrrolo [2,3-b]indol-3a-ol | 218.11 | 219.11 | [M+H]+ | C12H14N2O2 | 11.3 | 7.0 | 214 | 204.10; 194.11; 187.09 | 4.5 | 20.91% | [66] |
| 24 | 5-Ethyl-2,11,14-trimethyl-4,13,19,20-tetraoxatricyclo[14.2.1.17,10]icosane-3,12-dione | 382.24 | 383.24 | [M+H]+ | C21H34O6 | 32.3 | 5.0 | 228 | 368.39; 345.24; 325.21; 257.23; 251.19 | 4.9 | 44.44% | [67] |
| 25 | 5,7,3′,4′-Tetrahydroxy-8-methylisoflavon | 300.06 | 301.07 | [M+H]+ | C16H12O6 | 20.9 | 11.0 | 224 | 286.04; 271.08 | −0.1 | 65.17% | [68] |
| 26 | 5,7-dihydroxy-3′,5′-dihydroxyisoflavone | 286.05 | 287.05 | [M+H]+ | C15H10O6 | 18.4 | 16.0 | 224 | 269.04 | −1.6 | 91.50% | [69] |
| 27 | 5,7-Trihydroxy-3′,4′-dimethoxyisoflavone | 314.08 | 315.08 | [M+H]+ | C17H14O6 | 16.6 | 11.0 | 222 | 300.06; 270.16; 243.14 | −1.0 | 77.17% | [68] |
| 28 | Coronafacoyl-L-isoleucine | 321.20 | 322.20 | [M+H]+ | C18H27NO4 | 16.1 | 6.0 | 220 | 304.19 | 0.2 | 35.74% | [70] |
| 29 | (3S,6S)-3-benzyl-6-isopropylpiperazine-2,5-dione | 246.14 | 247.14 | [M+H]+ | C14H18N2O2 | 16.0 | 7.0 | 216 | 245.12 | −0.9 | 66.84% | [71] |
| 30 | N-Acetyl-3,4-dihydroxy-L-phenylalanine | 239.08 | 240.08 | [M+H]+ | C11H13NO5 | 15.7 | 6.0 | 222 | 199.08; 138.05 | −0.7 | 28.63% | [72] |
| 31 | 3-(1,3-benzodioxol-5-ylmethyl)-6-isopropyl-2,5-diketopiperazine | 290.13 | 291.13 | [M+H]+ | C15H18N2O4 | 14.6 | 8.0 | 220 | 285.11; 211.14; 125.07; 70.06 | −5.0 | 38.91% | [73] |
| 32 | N-salicyloyl-2-aminopropan-1-ol | 195.09 | 196.09 | [M+H]+ | C10H13NO3 | 9.3 | 5.0 | 212 | 174.97; 154.08 | −2.0 | 40.33% | [74] |
| S.N. | Annotated Compounds | Accurate Mass (Da) | Precursor Ion | Adduct Type | Formula | (Rt) (mins) | RDB | UV Absorption (nm) | Key Fragments | Error ppm | Sirius Score | References |
|---|---|---|---|---|---|---|---|---|---|---|---|---|
| 1 | Alaremycin | 186.07 | 187.07 | [M+H]+ | C8H11NO4 | 6.6 | 4.0 | 292 | 185.09 | 4.5 | 32.34% | [75] |
| 2 | Fumaramidmycin | 232.08 | 233.09 | [M+H]+ | C12H12N2O3 | 5.9 | 8.0 | 208 | 215.08; 188.07 | −1.3 | 27.84% | [76] |
| 3 | Anisomycin | 265.13 | 266.13 | [M+H]+ | C14H19NO4 | 18.1 | 6.0 | 222 | 249.14; 233.15; 222.129; 207.11 | −1.1 | 36.64% | [77,78] |
| 4 | Indolmycin | 257.12 | [M+H]+: 258.12; [M-H]−: 256.11 | [M+H]+; [M-H]− | C14H15N3O2 | 13.1 | 9.0 | 196; 216; 436 | [M+H]+: 170.06; 130.06; 120.08 [M-H]−: 127.05; 83.02 | −0.3 | 40.24% | [79] |
| 5 | 2-Acetamidobenzamide (NP-101A) | 178.07 | 179.07 | [M+H]+ | C9H10N2O2 | 6.5 | 6.0 | - | 174.98; 150.05 | −4.6 | 27.89% | [80] |
| 6 | 6-Acetylphenazine-1-carboxylic acid | 266.07 | 267.07 | [M+H]+ | C15H10N2O3 | 6.1 | 12.0 | - | 203.07 | −5.5 | 45.34% | [61] |
| 7 | Carbazomycin A | 256.13 | 257.13 | [M+H]+ | C16H17NO2 | 19.3 | 9 | 224 | 121.06 | −2.3 | 19.75% | [81] |
| 8 | Carpatamide B | 333.16 | 334.16 | [M+H]+ | C18H23NO5 | 17.4 | 8.0 | 222 | 316.15; 220.06; 208.09 | −1.2 | 38.52% | [82] |
| 9 | Pyramidamycin B | 183.05 | [M+H]+: 184.05; [M-H]−: 182.05 | [M+H]+; [M-H]− | C8H9NO4 | 8.4 | 5.0 | 292 | [M+H]+: 173.06; [M-H]−: 152.03, 136.04 | −1.4 | 28.13% | [83] |
| 10 | Streptokordin | 151.06 | [M+H]+: 152.07; [M-H]−: 150.06 | [M+H]+; [M-H]− | C8H9NO2 | 5.3 | 5.0 | 194, 292 | [M+H]+: 150.112, 95.06; [M-H]−: 122.06 | −3.2 | 32.96% | [84] |
| 11 | Spoxazomicin D | 206.06 | 205.06 | [M-H]− | C10H10N2O3 | 11.4 | 7.0 | 214, 436 | 99.02 | −0.2 | 38.80% | [83] |
| 12 | Cyclo(L-Tyr-L-Pro-L-Phe-trans-4-hydroxy-L-Pro) | 520.23 | 519.23 | [M-H]− | C28H32N4O6 | 11.2 | 15.0 | 210, 436 | 259.10, 153.06 | 0.7 | 64.24% | [85] |
| 13 | JBIR-75 | 234.11 | 235.11 | [M+H]+ | C11H14N4O2 | 5.8 | 7.0 | 208, 292 | 251.08, 188.07, 162.10 | −6.7 | 53.71% | [86] |
| 14 | 3097-B2 | 265.13 | 266.13 | [M+H]+ | C14H19NO4 | 18.1 | 6.0 | 222 | 249.14; 233.15; 222.129; 207.11 | −1.1 | 35.34% | [87] |
| 15 | 3-acetonylidene-7-prenylindolin-2-one | 256.13 | 257.13 | [M+H]+ | C16H17NO2 | 19.3 | 9 | 224 | 121.06 | −2.3 | 23.35% | [88] |
| 16 | N-salicyloyl-2-aminopropan-1,3-diol | 211.08 | [M+H]+: 212.09; [M-H]−: 210.08 | [M+H]+; [M-H]− | C10H13NO4 | 5.9 | 5.0 | 204, 294, 438 | [M+H]+: 152.07; [M-H]−: 168.06; 150.05 | −0.7 | 30.98% | [74] |
| 17 | 1-Acetoxy-N-salicyloyl-2-aminopropan-3-ol | 253.09 | [M+H]+: 254.10; [M-H]−: 252.09 | [M+H]+; [M-H]− | C12H15NO5 | 10.9 | 6.0 | 214 | [M+H]+: 194.08, 152.07; [M-H]−: 59.01 | −0.6 | 36.16% | [74] |
| 18 | 10-Deoxymethynolide | 296.19 | 295.19 | [M-H]− | C17H28O4 | 33.0 | 4.0 | 196 | 159.06 | 0.3 | 34.75% | [89] |
| 19 | N-Acetyl-tyramine; | 179.09 | 178.09 | [M-H]− | C10H13NO2 | 12.8 | 5.0 | 194, 278, 436 | 106.04, 58.03 | 0.4 | 87.01% | [62] |
| 20 | (2-aminophenyl)(2-ethyloxazol-5-yl)methanone | 216.08 | 215.08 | [M-H]− | C12H12N2O2 | 15.1 | 8.0 | 194, 436 | 173.07, 116.05 | 0.4 | 46.67% | [56,90,91] |
Publisher’s Note: MDPI stays neutral with regard to jurisdictional claims in published maps and institutional affiliations. |
© 2022 by the authors. Licensee MDPI, Basel, Switzerland. This article is an open access article distributed under the terms and conditions of the Creative Commons Attribution (CC BY) license (https://creativecommons.org/licenses/by/4.0/).
Share and Cite
Bhattarai, B.R.; Khadayat, K.; Aryal, N.; Aryal, B.; Lamichhane, U.; Bhattarai, K.; Rana, N.; Regmi, B.P.; Adhikari, A.; Thapa, S.; et al. Untargeted Metabolomics of Streptomyces Species Isolated from Soils of Nepal. Processes 2022, 10, 1173. https://doi.org/10.3390/pr10061173
Bhattarai BR, Khadayat K, Aryal N, Aryal B, Lamichhane U, Bhattarai K, Rana N, Regmi BP, Adhikari A, Thapa S, et al. Untargeted Metabolomics of Streptomyces Species Isolated from Soils of Nepal. Processes. 2022; 10(6):1173. https://doi.org/10.3390/pr10061173
Chicago/Turabian StyleBhattarai, Bibek Raj, Karan Khadayat, Niraj Aryal, Babita Aryal, Uttam Lamichhane, Keshab Bhattarai, Nabin Rana, Bishnu P. Regmi, Achyut Adhikari, Sandeep Thapa, and et al. 2022. "Untargeted Metabolomics of Streptomyces Species Isolated from Soils of Nepal" Processes 10, no. 6: 1173. https://doi.org/10.3390/pr10061173
APA StyleBhattarai, B. R., Khadayat, K., Aryal, N., Aryal, B., Lamichhane, U., Bhattarai, K., Rana, N., Regmi, B. P., Adhikari, A., Thapa, S., & Parajuli, N. (2022). Untargeted Metabolomics of Streptomyces Species Isolated from Soils of Nepal. Processes, 10(6), 1173. https://doi.org/10.3390/pr10061173











